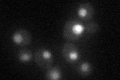
YOL090W
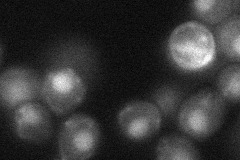
YOL090W
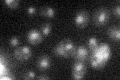
YOL090W

View description
Protein that forms heterodimers with Msh3p and Msh6p that bind to DNA mismatches to initiate the mismatch repair process; contains a Walker ATP-binding motif required for repair activity; Msh2p-Msh6p binds to and hydrolyzes ATP
Localization:
Intensity:
Fold change:
Significance:
-
C’ GFP library in SD
nucleus31.68 -
N' NOP1pr-GFP in SD

nucleus76.5596 -
N' TEF2pr-mCherry in SD

nucleus29.2349 -
N' NATIVEpr-GFP in SD

nucleus38.2923 -
N' TEF2pr-VC and Cyto-VN in SD
nucleus33.5377 -
C’ GFP library in SD+DTT

nucleus36.371.14No -
C’ GFP library in SD+H2O2

nucleus35.711.12No -
C’ GFP library in Starvation Media
nucleus24.910.78No -
C’ GFP library on the background of Pup2-DaMP

nucleus -
C’ GFP library on the background of CCT mutant

nucleus36.80541.16152No
